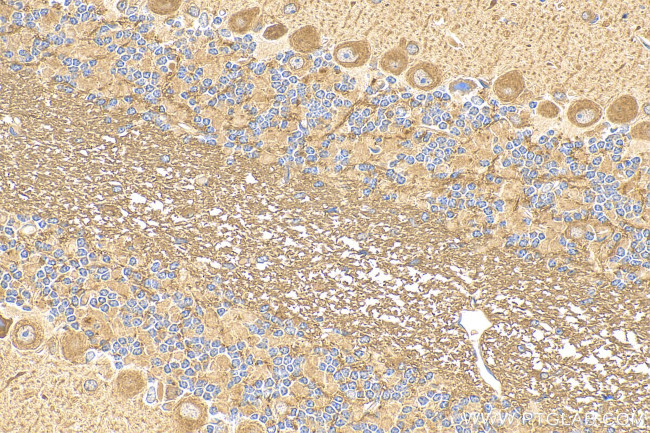
KIAA1715 Antibody in Immunohistochemistry (Paraffin) (IHC (P))

Search
Proteintech
KIAA1715 Polyclonal Antibody
{{$productOrderCtrl.translations['antibody.pdp.commerceCard.promotion.promotions']}}
{{$productOrderCtrl.translations['antibody.pdp.commerceCard.promotion.viewpromo']}}
{{$productOrderCtrl.translations['antibody.pdp.commerceCard.promotion.promocode']}}: {{promo.promoCode}} {{promo.promoTitle}} {{promo.promoDescription}}. {{$productOrderCtrl.translations['antibody.pdp.commerceCard.promotion.learnmore']}}
产品信息
30857-1-AP
种属反应
宿主/亚型
分类
类型
抗原
偶联物
形式
浓度
规格
纯化类型
保存液
内含物
保存条件
运输条件
产品详细信息
Immunogen sequence: RTERNNEALD DLKSQRKKIL EEVMEKETYK TAKLILERFD PDSKKAKECE PPSAGAAVTA RPGQEIRQRT AAQRNLSPTP ASPNQGPPPQ VPVSPGPPKD SSAPGGPPER TVTPALSSNV LPRHLGSPAT SVPGMGLHPP GPPLARPILP RERGALDRIV EYLVGDGPQN RYALICQQCF SHNGMALKEE FEYIAFRCAY CFFLNPARKT RPQAPRLPEF SFEKRQVVEG SSSVGPLPSG SVLSSDNQFN EESLEHDVLD DNTEQTDDKI PATEQTNQVI EKASDSEEPE EKQETENEEA SVIETNSTVP GADSIPDPEL SGESLTAE
靶标信息
LNP (LNPK) is an endoplasmic reticulum (ER)-shaping membrane protein that plays a role in determining ER morphology. It is involved in the stabilization of nascent three-way ER tubular junctions within the ER network and may play a role as a curvature-stabilizing protein within the three-way ER tubular junction network. LNP is involved in central nervous system development and may be involved in limb development.
仅用于科研。不用于诊断过程。未经明确授权不得转售。
篇参考文献 (0)
生物信息学
蛋白别名: 2310011O18Rik; 4921514L11Rik; Endoplasmic reticulum junction formation protein lunapark; ER junction formation factor lunapark; limb and neural patterns; lunapark; protein lunapark; Protein ulnaless; unnamed protein product
基因别名: 2310011O18Rik; 4921514L11Rik; 9530051D01Rik; AI666268; KIAA1715; LNP; LNP1; LNPK; NEDEHCC; Ul; Uln; ulnaless
UniProt ID: (Human) Q9C0E8, (Mouse) Q7TQ95
Entrez Gene ID: (Human) 80856, (Mouse) 69605